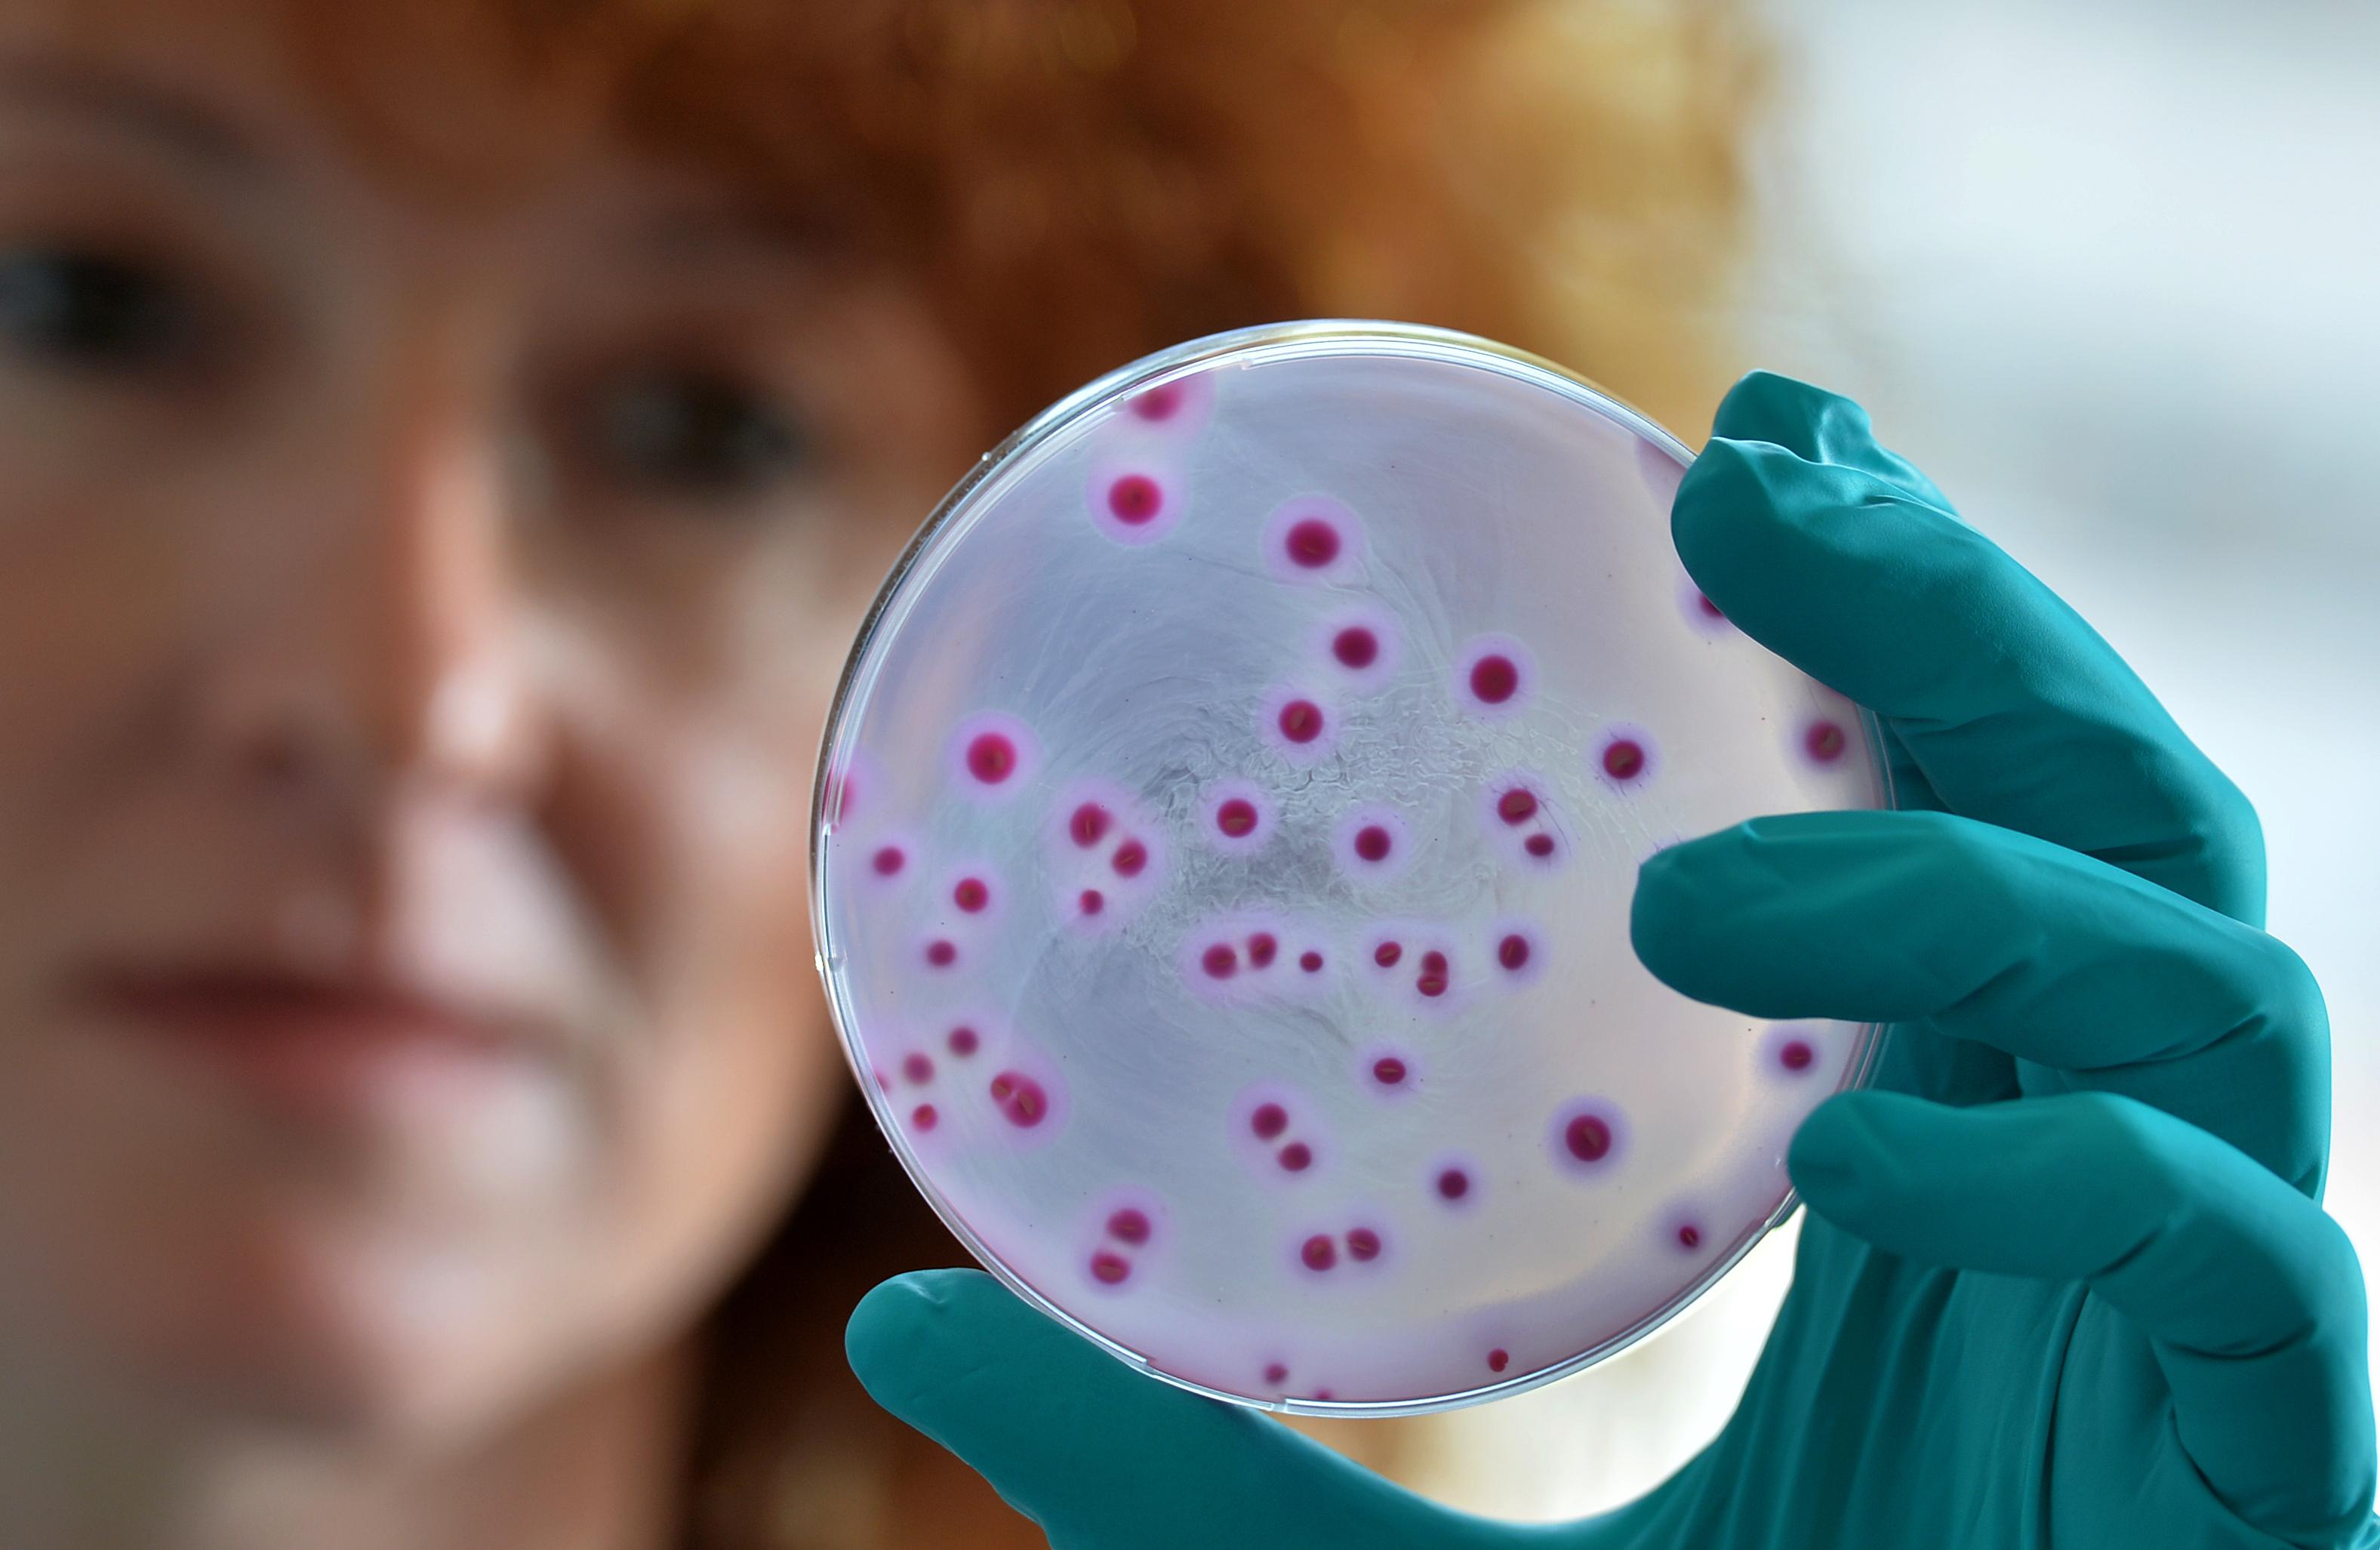
Eine Frau hält eine Schale mit einem speziellen Nährboden für Escherichia coli Bakterien

Eine dauerhafte Bindung an die Ribosomen von Bakterien – das ist es, was Cresomycin von herkömmlichen Antibiotika unterscheidet. Offenbar eignet es sich dadurch sehr gut als Antibiotikum gegen multiresistente Keime. Denn: Bisherige Medikamente verloren ihre Wirkung oft aufgrund von Veränderungen der Bindungsstellen.
Entworfen wurde das neue synthetische Molekül von einem Forschungsteam der Harvard-Universität. In der Fachzeitschrift "Science" beschreiben (externer Link, möglicherweise Bezahl-Inhalt) die Forschenden ihre Entdeckung.
- Zum Artikel: "Multiresistente Keime: Forschung setzt Hoffnung auf KI"
Molekül wurde computergestützt entworfen
Die Wissenschaftler und Wissenschaftlerinnen hatten zunächst diese Bindungsstellen von Antibiotika-Molekülen erfasst. Anschließend entwickelten sie mithilfe computergestützter Methoden ein Molekül, das optimal in diese Stellen passt. Das Cresomycin genannte Antibiotikum hat das Team nun an Mäusen getestet – mit großem Erfolg. Das Molekül, abgekürzt CRM, sei gegen multiresistente Stämme von etwa Staphylococcus aureus, Escherichia coli und Pseudomonas aeruginosa wirksam.
Zunächst wird Cresomycin weiterentwickelt werden, bald sollen klinische Tests folgen. Die Hoffnung der Forschenden: Dass das Super-Antibiotikum auch beim Menschen sicher und wirksam ist. Erste Erkenntnisse hierzu geben Hoffnung: In menschlichen Zellkulturen konnte Cresomycin das Wachstum multiresistenter Bakterien stoppen.
Kasse besorgt wegen Verschreibungen von Reserveantibiotika
Erst kürzlich hatte sich die bayerische AOK-Krankenkasse besorgt geäußert angesichts von Verordnungen sogenannter Reserveantibiotika. Es handelt sich dabei um besonders stark wirkende Arzneien gegen multiresistente Bakterien. Sie wurden 2022 in 46 Prozent aller Antibiotika-Verschreibungen verordnet und damit zwar seltener als noch 2019. Jedoch würden Ärzte und Ärztinnen diese Medikamente vielfach zu sorglos verwenden. Bei übermäßigem Einsatz würden Bakterien resistenter gegen Antibiotika.
Auch die Belastung von Gewässern und Abwasser mit antibiotischen Stoffen gefährdet die Wirkung von Antibiotika, wenn sich multiresistente Keime über dieses Wasser ausbreiten. Eine Pilotstudie zeigt: An 40 Prozent der untersuchten Arzneimittel-Produktionsstätten hätten sich teils massive Überschreitungen vertraglich zugesicherter maximaler Wirkstoffkonzentrationen im Produktionsabwasser gezeigt. Das teilte die AOK Baden-Württemberg nach einem Projekt mit dem Rheinisch-Westfälischen Institut für Wasserforschung und dem Umweltbundesamt mit. Notwendig seien Änderungen im EU-Arzneimittelrecht mit verbindlichen Umweltkriterien sowie einheitliche Kontrollsysteme.
Mit Informationen von dpa
Das ist die Europäische Perspektive bei BR24.
"Hier ist Bayern": Der BR24 Newsletter informiert Sie immer montags bis freitags zum Feierabend über das Wichtigste vom Tag auf einen Blick – kompakt und direkt in Ihrem privaten Postfach. Hier geht’s zur Anmeldung!